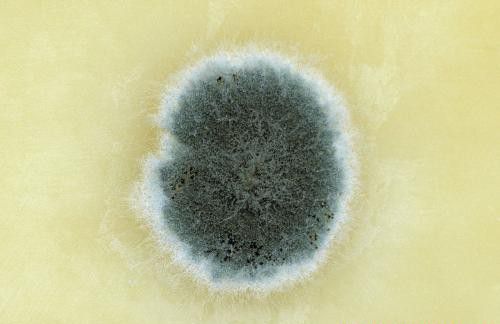
种植如何防治青霉？

种植如何防治青霉?
青霉在食用菌栽培中发生普遍,是灵芝等食用菌芝床上的重要病害,近期有种植灵芝的网友咨询:青霉菌对灵芝生产有哪些影响,青霉对灵芝生长有哪些危害?青霉菌有哪些特征,青霉菌发生规律是怎么样?灵芝栽培中如何预防青霉发生,栽培灵芝过程中发生青霉怎么办?以下想种菜网就作简单介绍,供网友们参考。

青霉对灵芝的危害
危害灵芝的青霉种类较多,主要有绳状青霉、产黄青霉、圆弧状青霉等。在采收时,留在栽培床上的芝根容易染病,染病后逐渐侵染病体附近的健体。一般从健康灵芝的菌柄基部侵入,后发生黄褐色腐烂,并由基部向上扩展。青霉分生孢子主要靠空气传播,全年均可造成危害,但在高温季节造成的危害最严重。
青霉的发生规律
青霉病菌喜酸性,酸性培养料和含水偏低的条件有利于病菌发生和蔓延。在出芝期间,培养料含水分偏低、空气相对湿度过低、幼芝生长衰弱、残留在芝床上的芝根未及时清除时,有利于病害的发生。

防治灵芝青霉措施:
1、灵芝采收后,及时清理栽培场所,将瘦弱的幼芝及残留的芝根清除,减少病菌的发生。
2、培养料要求新鲜、干燥。配料时水分要湿透拌匀,不能有干料;培养料需在100℃左右高温下灭菌10小时以上。
3、合理调节培养料的酸碱度,控制培养基呈中性至弱碱性反应,可以抑制该病菌的菌丝生长。可用石灰调节培养料的酸碱度,拌料时加入1%的石灰,采完第一潮灵芝后,喷洒一次2%的石灰水清液1次。
4、接种场所和培养室在使用之前用气雾消毒盒点燃熏蒸消毒,或者用甲醛与高锰酸钾混合产生气体进行熏蒸消毒。也可喷洒0.1%多菌灵液或0.25%新洁尔灭液,杀死环境中青霉菌孢子。
5、加强栽培管理,在芝蕾和芝盖形成阶段,在栽培室的地面喷洒水,保持湿润,适时通风透气。
6、出现青霉感染后,及时挖出培养料,加入新鲜培养料中混合,经灭菌后再利用,也可烧毁或埋入土中。
7、在发病后,可在芝床上喷洒25%多菌灵500倍液,或70%甲基托布津800倍液。
以上就是想种菜网对灵芝的介绍,如您有更好的补充请在下方留言告诉我们。
